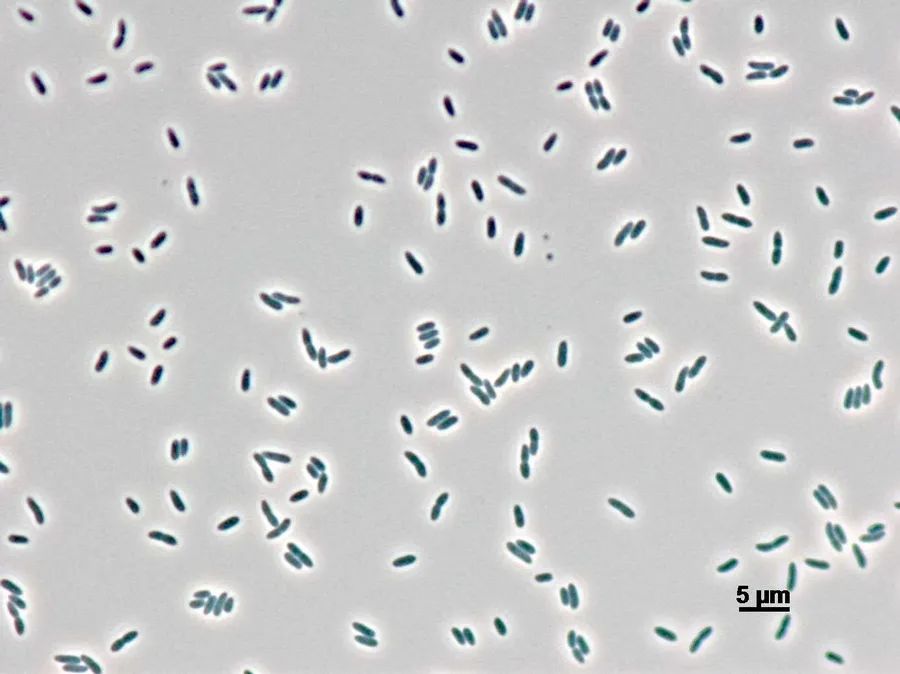

微信掃描二維碼,點(diǎn)擊右上角 ··· 按鈕
轉(zhuǎn)發(fā)給朋友或分享到朋友圈
顯微成像·洞察微觀之美
Microscopic imaging, insight into the beauty of micro
吃貨也得講技術(shù),為什么泡久了的河粉、木耳易中毒?
發(fā)布時(shí)間:2025-11-07
訪問量:297
吃貨也得講技術(shù),為什么泡久了的河粉、木耳易中毒?
每年夏天都免不了食物中毒的新聞,除了吃毒蘑菇導(dǎo)致中毒,還有因?yàn)槌愿粢购臃?米粉導(dǎo)致中毒。毒蘑菇顧名思義本身就是有毒,隔夜的河粉、米粉和久泡的木耳,為什么也容易中毒呢?今天我們就來科普一下。
01
微生物污染:椰毒假單胞菌

發(fā)酵食品容易受微生物污染
在生活環(huán)境中,微生物其實(shí)無所不在,暴露在適當(dāng)?shù)臏囟葷穸认拢澄锞蜁?huì)發(fā)酵。

泡發(fā)的米粉河粉木耳,可能會(huì)發(fā)酵
有時(shí)這個(gè)結(jié)果是好的,比如6000年前,大麥面包的發(fā)酵讓蘇美爾人學(xué)會(huì)了制作啤酒,有時(shí)這個(gè)結(jié)果是糟糕的,比如隔夜的河粉、米粉和久泡的木耳,就是因?yàn)榘l(fā)酵而變成有毒,而罪魁禍?zhǔn)拙褪且炯賳伟兔酌鎭喎N。

電子顯微鏡下的椰毒假單胞菌
椰毒假單胞菌名字可能有點(diǎn)拗口,“椰毒”是因?yàn)檫@個(gè)細(xì)菌最初是印尼在椰子肉發(fā)酵食品中發(fā)現(xiàn)的,而在國內(nèi)同樣在酵米面中發(fā)現(xiàn)了這種細(xì)菌,故稱椰毒假單胞菌酵米面亞種,野生的鮮黑木耳/銀耳、生濕的河粉等米面制品,都容易被這種菌污染。
02
毒性原理:兩種毒性產(chǎn)物

米酵菌酸(BA)毒性原理,American College of Medical Toxicology 2017
椰毒假單胞菌本身可以被烹飪的高溫殺死,但其產(chǎn)生的毒素比較耐高溫,因此即便經(jīng)過加熱,吃了還是會(huì)中毒。
03
如何檢測(cè)椰毒假單胞菌

國標(biāo)檢測(cè)方法:培養(yǎng)觀察試毒
按國標(biāo)GB 4789.29-2020,椰毒假單胞菌可以分為6步,首先是檢樣,使用增菌液培養(yǎng),再分離接種到mPDA或者PCFA平板,然后使用革蘭氏染色結(jié)合氧化酶試驗(yàn)初篩,再接種到PDA平板,進(jìn)行生化實(shí)驗(yàn)或者毒性實(shí)驗(yàn),最后輸出結(jié)果報(bào)告。

顯微鏡下革蘭氏染色的椰毒假單胞菌
椰毒假單胞菌是革蘭氏陰性、氧化酶陽性的細(xì)菌,在生物顯微鏡ML31顯微鏡鏡檢下呈現(xiàn)為粉紅色到紅色的短桿狀。
相差觀察下的椰毒假單胞菌
使用相差配置的ML31生物顯微鏡,可以不經(jīng)染色直接觀察椰毒假單胞菌,但大部分實(shí)驗(yàn)室都不會(huì)有100X的相襯顯微鏡,且相襯觀察形態(tài)難以準(zhǔn)確區(qū)分細(xì)菌,因?yàn)閷?shí)際意義不大。

熒光染色的椰毒假單胞菌(綠)
在微生物研究中,可以使用MF31等熒光生物顯微鏡,搭配CY3等熒光染料,對(duì)椰毒假單胞菌進(jìn)行特異性熒光標(biāo)記,以示蹤其分布和變化。目前市面有基于熒光擴(kuò)增的快速測(cè)試盒,相比培養(yǎng)法更快,但成本較高,因此沒有得到很廣泛的使用。

熒光顯微鏡MF31
綜上,隔夜的河粉、米粉和久泡的木耳有毒是因?yàn)橐炯賳伟?,其檢測(cè)目前還存在時(shí)間成本和物料成本上的限制,等培養(yǎng)和觀察都做完,可能都已經(jīng)吃完并且毒性發(fā)作完了,因此我們能做的不是用顯微鏡等手段檢測(cè)有沒有椰毒假單胞菌,而是默認(rèn)隔夜的河粉、米粉和久泡的木耳有椰毒假單胞菌,不要去食用。
微信掃描二維碼,點(diǎn)擊右上角 ··· 按鈕
轉(zhuǎn)發(fā)給朋友或分享到朋友圈